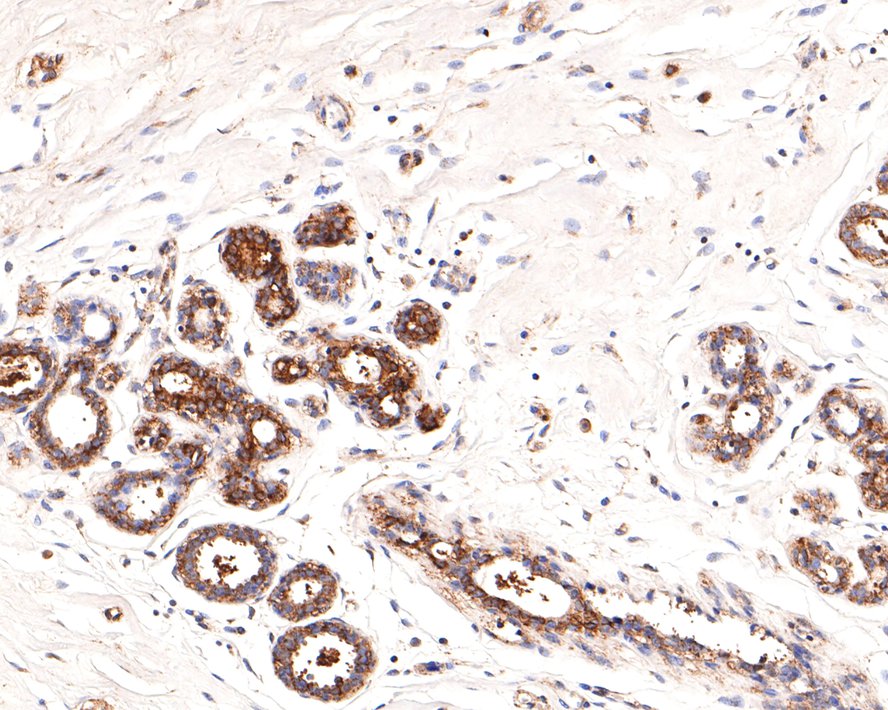

图片
-
Western blot analysis of IRAK-1 on 293T cell lysates with Rabbit anti-IRAK-1 antibody (HA500377) at 1/2,000 dilution.
Lysates/proteins at 10 µg/Lane.
Predicted band size: 77 kDa
Observed band size: 77 kDa
Exposure time: 1 minute;
8% SDS-PAGE gel.
Proteins were transferred to a PVDF membrane and blocked with 5% NFDM/TBST for 1 hour at room temperature. The primary antibody (HA500377) at 1/2,000 dilution was used in 5% NFDM/TBST at room temperature for 2 hours. Goat Anti-Rabbit IgG - HRP Secondary Antibody (HA1001) at 1:300,000 dilution was used for 1 hour at room temperature.
-
Immunohistochemical analysis of paraffin-embedded rat brain tissue with Rabbit anti-IRAK-1 antibody (HA500377) at 1/400 dilution.
The section was pre-treated using heat mediated antigen retrieval with Tris-EDTA buffer (pH 9.0) for 20 minutes. The tissues were blocked in 1% BSA for 20 minutes at room temperature, washed with ddH2O and PBS, and then probed with the primary antibody (HA500377) at 1/400 dilution for 1 hour at room temperature. The detection was performed using an HRP conjugated compact polymer system. DAB was used as the chromogen. Tissues were counterstained with hematoxylin and mounted with DPX.
-
Immunohistochemical analysis of paraffin-embedded human breast tissue with Rabbit anti-IRAK-1 antibody (HA500377) at 1/800 dilution.
The section was pre-treated using heat mediated antigen retrieval with Tris-EDTA buffer (pH 9.0) for 20 minutes. The tissues were blocked in 1% BSA for 20 minutes at room temperature, washed with ddH2O and PBS, and then probed with the primary antibody (HA500377) at 1/800 dilution for 1 hour at room temperature. The detection was performed using an HRP conjugated compact polymer system. DAB was used as the chromogen. Tissues were counterstained with hematoxylin and mounted with DPX.
-
Immunohistochemical analysis of paraffin-embedded mouse large intestine tissue with Rabbit anti-IRAK-1 antibody (HA500377) at 1/400 dilution.
The section was pre-treated using heat mediated antigen retrieval with Tris-EDTA buffer (pH 9.0) for 20 minutes. The tissues were blocked in 1% BSA for 20 minutes at room temperature, washed with ddH2O and PBS, and then probed with the primary antibody (HA500377) at 1/400 dilution for 1 hour at room temperature. The detection was performed using an HRP conjugated compact polymer system. DAB was used as the chromogen. Tissues were counterstained with hematoxylin and mounted with DPX.
-
Immunocytochemistry analysis of Hela cells labeling IRAK-1 with Rabbit anti-IRAK-1 antibody (HA500377) at 1/100 dilution.
Cells were fixed in 4% paraformaldehyde for 10 minutes at 37 ℃, permeabilized with 0.05% Triton X-100 in PBS for 20 minutes, and then blocked with 2% negative goat serum for 30 minutes at room temperature. Cells were then incubated with Rabbit anti-IRAK-1 antibody (HA500377) at 1/100 dilution in 2% negative goat serum overnight at 4 ℃. Goat Anti-Rabbit IgG H&L (iFluor™ 488, HA1121) was used as the secondary antibody at 1/1,000 dilution. Nuclear DNA was labelled in blue with DAPI.
Beta tubulin (M1305-2, red) was stained at 1/100 dilution overnight at +4℃. Goat Anti-Mouse IgG H&L (iFluor™ 647, HA1127) were used as the secondary antibody at 1/1,000 dilution.
-
Immunocytochemistry analysis of PC-3M cells labeling IRAK-1 with Rabbit anti-IRAK-1 antibody (HA500377) at 1/100 dilution.
Cells were fixed in 4% paraformaldehyde for 10 minutes at 37 ℃, permeabilized with 0.05% Triton X-100 in PBS for 20 minutes, and then blocked with 2% negative goat serum for 30 minutes at room temperature. Cells were then incubated with Rabbit anti-IRAK-1 antibody (HA500377) at 1/100 dilution in 2% negative goat serum overnight at 4 ℃. Goat Anti-Rabbit IgG H&L (iFluor™ 488, HA1121) was used as the secondary antibody at 1/1,000 dilution. Nuclear DNA was labelled in blue with DAPI.
Beta tubulin (M1305-2, red) was stained at 1/100 dilution overnight at +4℃. Goat Anti-Mouse IgG H&L (iFluor™ 647, HA1127) were used as the secondary antibody at 1/1,000 dilution.
请注意: All products are "FOR RESEARCH USE ONLY AND ARE NOT INTENDED FOR DIAGNOSTIC OR THERAPEUTIC USE"